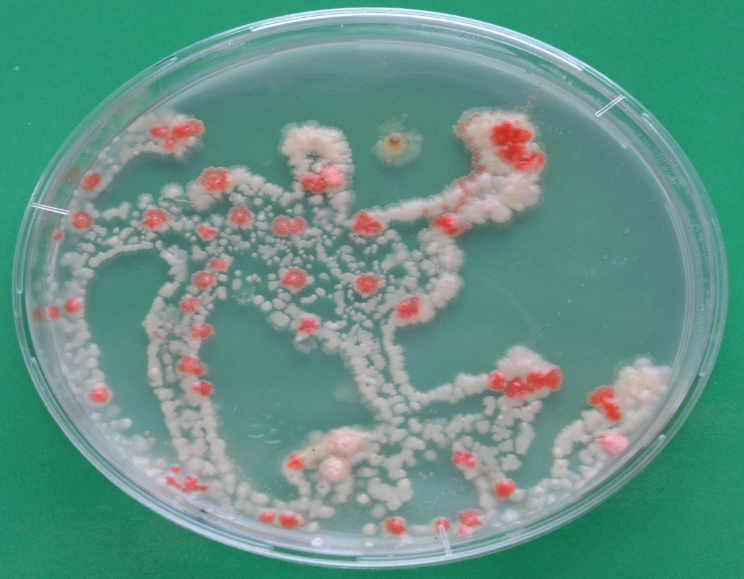
1709894263-glive-petri.png

Prof. dr. Nina Gunde-Cimerman je svojo kariero posvetila glivam, ki uspevajo v ekstremnih okoljih. Njena raziskovanja so jo vodila od Sečoveljskih solin do arktičnega kroga, pozornost svetovne javnosti pa je pritegnila tudi z ugotovitvijo, da v večini pomivalnih strojev na svetu živijo glive, ki so lahko zelo nevarne. Biotehniška fakulteta ji bo letos podelila Jesenkovo nagrado za življenjsko delo. V intervjuju za N1 razlaga o življenju v naših pomivalnih strojih in o tem, zakaj uporabo pomivalnih strojev odsvetuje za nedonošenčke in bolnike z oslabljenim imunskim sistemom. O glivah, ki jih je našla tam, kjer jih še nihče prej ni našel, in o možnosti življenja na Marsu.
Glive ste našli v solinah, grenčici, arktičnem ledu, oblakih, jamah, pomivalnih strojih. Ali je kakšno okolje, ki je dovolj negostoljubno zanje?
Še največja ovira zanje so visoke temperature. Znano je, da določene vrste arhej preživijo do 123 stopinj Celzija. To je trenutno zgornja meja življenja. Kar zadeva evkarionte, pa velja, da je zgornja meja življenja 60 stopinj. Ampak tudi to ne drži povsem. Če so namreč v izsušenem stanju ali v obliki biofilma, preživijo tudi na višjih stopinjah.
O tem še ne vemo veliko. Prijavili smo projekt, v katerem bi preizkušali ravno to, kako zmrzovanje in izsuševanje vplivata na njihovo preživetje na visokih temperaturah. Najbolj negostoljubna okolja zanje so vulkani in vroči termalni vrelci.
Lani poleti sem bila na visokih planotah Bolivije, kjer smo prvič na svetu vzorčili slana zmrznjena okolja. Poleg natrijevega klorida je tam prisoten tudi litijev diklorid, o katerem vemo zelo malo. Tam je tudi boraks, ki so ga stoletja uporabljali kot antiseptik. V tisti vodi smo našli mikroorganizme.
Kaj preživi v vašem pomivalnem stroju?
Čeprav, kot pravite, glivam vroča okolja ne ustrezajo, ste nekatere vrste našli tudi v pomivalnih strojih, kjer naj bi bile temperature relativno visoke.
V pomivalnih strojih smo našli pet vrst oportuno patogenih gliv, kar pomeni, da pri ljudeh z oslabljenim imunskim sistemom lahko povzročajo bolezni. Presenetljivo je bilo, da smo iste vrste našli na tako rekoč vseh celinah. Ljudje jejo povsem različno hrano, imajo različno vodo, različna notranja okolja, a povsod je istih pet vrst gliv.
To pomeni, da pomivalni stroj deluje na način, da pobije vse, razen teh pet vrst, ki so se očitno odlično prilagodile. Lahko rečemo, da so postale neke vrste naše domače živali, z nami živijo in moramo se eni na druge prilagajati.
[caption id="attachment_6413656" align="aligncenter" width="1024"]
Nina Gunde-Cimerman (Foto: Jan Gregorc/N1)[/caption]
Dr. Nina Gunde-Cimerman je redna profesorica za področje mikrobiologije na Biotehniški fakulteti Univerze v Ljubljani in od leta 2016 vodja katedre za molekularno genetiko in biologijo mikroorganizmov na oddelku za biologijo Biotehniške fakultete, v okviru katere vodi raziskovalno skupino za biologijo mikroorganizmov. Poleg tega je vodja Infrastrukturnega centra Mycosmo, delujočega v okviru Mreže infrastrukturnih centrov Univerze v Ljubljani. Znotraj tega dr. Gunde-Cimerman vodi strokovno delo na področju mikrobioloških in mikoloških analiz v sodelovanju s slovensko (npr. Gorenje, Union, Calcit) in tujo (npr. Electrolux, Resilux) industrijo in raziskovalnimi institucijami.
Ali zaradi tega komu odsvetujete uporabo pomivalnega stroja?
Če ima nekdo res oslabljen imunski sistem, ker ima denimo raka in se zdravi s kemoterapijo, bi uporabo pomivalnega stroja odsvetovala. Enako za nedonošenčke in zelo majhne dojenčke. V teh primerih bi bila previdna.
Tudi zato, ker če imamo pomivalni stroj, je v kuhinji drugačna flora. Ko po pomivanju stroj odpreš, gre ven aerosol, v katerem so te celice. Tudi tam, kjer stroja ni, so glive. Tam prevladuje kandida.
Dejstvo je, da se aseptično ne da živeti, tako da nima smisla biti preveč prestrašen. Je pa naše okolje zaradi tega drugačno.
Kako torej čistiti pomivalni stroj?
Kako lahko skrbimo za pomivalne stroje, da razraščanje teh gliv zajezimo?
Smiselno je, da vsaj občasno operemo prazen stroj, in to na čim višji temperaturi. Ko čistimo notranje dele, je najbolje, da jih pobrišemo s kisom. Acetat, molekula, ki je v kisu, je zelo majhna in prodira skoz membrane in na ta način uspešno uniči mikroorganizme.
Sama se držim teh načel. Stroj vsekakor še vedno uporabljam. (smeh)
Bi lahko industrija naredila več?
Pri pomivalnih strojih pravzaprav niti ne. Tesnila, na katerih se naredijo biofilmi teh gliv, so sintetične gume, ki že v osnovi vsebujejo nekatere biocide. Tem mikroorganizmom se kljub temu uspe zavarovati pred njimi. Tukaj se torej prav veliko ne da narediti.
Vemo, da mikroorganizmi v stroj pridejo z vodo iz vodovoda. V trdi vodi, ki ima več karbonatov, so večje koncentracije mikroorganizmov kot v mehki vodi. Bolj je voda trda, več je torej možnosti, da se te glive naselijo v stroj. A filtri, ki bi to lahko preprečili, se sčasoma zamašijo, zato bi jih bilo treba ves čas menjavati. Zaenkrat to ni smiselna rešitev.
Problem je tudi odpadna voda, ki se iz stroja odvaja v kanalizacijo. Vemo, da je ta voda koncentrat mikroorganizmov.
Smiselno bi bilo zmanjšati to breme za okolje. Tukaj še ni bilo narejenega dovolj.

Industrija nad vašim člankom o pomivalnih strojih sprva ni bila navdušena ...
Milo rečeno. (smeh)
Vendar pa zdaj dobro sodelujete.
Drži, zdaj lahko rečem, da imamo vzorno sodelovanje. Ukvarjamo se recimo z razvojem pralnih in sušilnih strojev, v katerih se med pranjem mikroorganizmi ne bi ohranjali na perilu. Če peremo pri eko temperaturah, namreč ne pobijemo mikroorganizmov, vemo pa, da nekatere materiale moramo prati pri nizkih temperaturah, sicer se uničijo.
V preteklosti učinkovitosti pranja niso preizkušali prek prisotnosti mikrobov ali pa so to počeli z neustreznimi vrstami mikrobov. Zdaj se to dela z mikroorganizmi, ki so bolj relevantni.
Torej moramo tudi perilo prati na čim višjih temperaturah?
Vem, da to ne zveni okolju prijazno, a vsaka stvar ima dve plati. Najbolje je, da uporabljamo naravne tkanine, ki jih lahko peremo na višjih temperaturah. Konec koncev je to tudi okolju najbolj prijazno. Pri vsakem pranju sintetičnih oblačil se namreč sproščajo velike količine mikrodelcev, mikroplastike, ki prehaja v okolje.
Izkazalo se je sicer, da so ekstremofilne glive zelo dobra izbira tudi za razgradnjo plastike.
Ste pravzaprav ustanoviteljica povsem novega znanstvenega področja – mikrobiologije ekstremofilnih gliv. Ko ste v solnici Sečoveljskih solin identificirali glivo črno kvasovko, je to ovrglo dotedanje ustaljeno prepričanje, da v takšnem okolju glive ne morejo živeti. Zakaj ste vi menili, da lahko?
Razmišljala sem zelo preprosto. Če plesen ali drug mikroorganizem zraste na salami, pršutu ali na marmeladi, sem si rekla, zakaj pa v naravnem okolju to ne bi bilo možno? Bila sem še dovolj naivna v pozitivnem smislu in pred tem nisem prebrala že vse literature, v kateri je pisalo, da gliv v takšnih okoljih še nihče ni našel.
Iz solinskih vod smo tako izolirali glive, predvsem črne kvasovke. Šele potem ko smo začeli preučevati literaturo, smo ugotovili, da jih tam ne bi smelo biti. Trajalo je kar dolgo, da smo znanstveno srenjo prepričali, da je to to.
Logika za mojim razmišljanjem je bila preprosta, ni bila pa slaba.

Rastlina ni le rastlina, ampak obstaja s svojimi mikroorganizmi
To odkritje ima tudi povsem uporabno vrednost. Recimo v kmetijstvu.
Res je. Zaradi podnebnih sprememb moramo vedno več tal umetno namakati, saj so sicer presuha za gojenje rastlin. Ker ne namakamo z destilirano vodo, to počasi vodi v zasoljevanje. Tla postajajo vse bolj slana.
Če so tla slana, je to velik stres za rastline. Tako rekoč nobena rastlina, ki jo pridelujemo za hrano, na takih tleh ne more uspevati. S preučevanjem halofilnih, slanoljubnih gliv, ki so relativno podobne rastlinam, lahko določimo tarče v genomu, ki se jih izplača izboljševati, zato da bo rastlina bolj sposobna rasti na slanih tleh.
Zdaj namreč že zelo dobro vemo, kako se gliva spremeni, zato da je prilagojena na slano okolje. Pred leti smo tako s sodelavci z ljubljanske medicinske fakultete, nacionalnega inštituta za biologijo in s sodelavci v Belgiji ustvarili rastlino, ki je na slanih tleh rasla bistveno bolje kot tista nespremenjena.
To pa ni edina uporabna vrednost. Danes se veliko bolj kot nekoč zavedamo, da je rastlina holobiont. To pomeni, da rastlina ni le rastlina, ampak da obstaja s svojimi mikroorganizmi – torej s tistimi v rastlini, na površini listov in v kombinaciji s koreninami.
V sodelovanju z Mehičani, Bolivijci in Portugalci iščemo mikroorganizme, ki so prilagojeni na sušnost in na slanost, da bi jih lahko kot simbiotske organizme uporabili v pomoč pri rasti. S temi bi lahko nadomestili "standardne" mikroorganizme rastline. Na bolivijskih planotah smo izolirali nekatere takšne mikroorganizme, ki zdaj v enem od bolivijskih laboratorijev pomagajo kvinoji pri rasti.

Te glive pa so uporabne tudi pri skladiščenju sadja. Recimo jabolka se pri skladiščenju poškropijo s kemijskimi snovmi, da se na njih ne bi razvijali patogeni organizmi. Uporabimo pa lahko tudi biokontrolne mikroorganizme, ki so za zdravje neškodljivi. Ti prerastejo površino sadja, s čimer zavirajo rast nezaželenih mikroorganizmov. V ta namen se običajno uporabljajo standardne glive.
Zdaj smo naredili lepo serijo poskusov, tudi v sodelovanju s Kmetijskim inštitutom, kjer smo v ta namen uporabili glivo z arktičnih ledenikov. Ta učinkovito zavira rast patogenih organizmov, ob tem pa je bistveno bolje prilagojena na pogoje v hladilnicah.
Mikroorganizme, ki so prilagojeni na slanost, bi lahko uporabljali tudi za sanacijo onesnaženja z naftnimi derivati, ki se zgodijo na slanih območjih.
Torej bi z ekstremofilnimi glivami lahko čistili razlitje nafte v morju?
Tudi do neke mere. Zdaj se za to uporabljajo bakterije, ki so gensko predelane. Zagotovo pa bi bili še bolj smiselni konzorciji mikroorganizmov.
Gliv, ki lahko rastejo pri naši telesni temperaturi, je zelo malo
Ali segrevanje ozračja vpliva na razvoj gliv?
Absolutno.
Ljudje smo pred glivnimi okužbami zaščiteni s telesno temperaturo. To je naša glavna obramba. Gliv, ki lahko rastejo pri naši telesni temperaturi, je zelo malo. Od 120.000 znanih gliv je takšnih recimo 200.
Ko smo v solinah odkrili črno kvasovko, je veljalo, da raste na visoki slanosti in na temperaturah do 30 stopinj Celzija, ne več. Potem je prišla doktorandka, ki je testirala rast te glive pri 37 stopinjah in na slanem gojišču. In naenkrat je ta gliva rasla tudi pri 37 stopinjah, če le je bilo okolje slano.
Zdaj pripravljamo članek s sodelavci iz Katarja, ki so to glivo izolirali iz vode, ki ima 43 stopinj. Prepričana sem, da pred 20 leti to ne bi bilo mogoče in da je to, kar vidimo, postopno prilagajanje na drugačno okolje.
Tretjina Grenlandije je črna zaradi alg
Za človeka to najbrž ne pomeni nič dobrega.
Prav dobro ni.
Bolj kot se ozračje segreva, večja je selekcija – nekateri organizmi se prilagodijo, drugi odpadejo.
Angleži so z več študijami pokazali, da se gobe zdaj pojavljajo čisto drugače, kot so se nekoč. Nekatere gobe, ki so se prej pojavljale samo jeseni, se zdaj tudi spomladi. Nekatere, ki so se prej pojavljale v obdobju 30 dni, se zdaj v obdobju 50 dni. Ti vzorci se spreminjajo.
Podobno kaže naša raziskava na Grenlandiji. Pred leti smo bili povabljeni k projektu Black and Bloom, ki se je ukvarjal z dejstvom, da je tretjina Grenlandije črna. Črna je zaradi alg, ki se tam zaradi vedno večjega deleža vode na ledu, ki nastaja zaradi taljenja, čedalje hitreje širijo.
Te alge so prvič opisali že okrog leta 1870, torej niso nič novega. V zadnjih 20 letih pa so se od tega, da je bila ena zaplata tukaj in druga tisoč kilometrov stran, razširile na tretjino Grenlandije. Grenlandija ima 1.600.000 kvadratnih kilometrov, samo predstavljajte si, za kakšno območje gre. Jasno je, da če se nekaj dogaja na tako velikem območju, bo imelo tudi globalni vpliv.

"Glive so estetske, so lepe ... in bile so prezrte"
Znanstveno kariero ste posvetili preučevanju gliv. Kaj vas tako fascinira na njih?
Ko sem se na fakulteti prvič srečala z glivami, me je fasciniralo, kako estetske so. Res so lepe. Imajo tudi neverjetno sposobnost prilagajanja na vse mogoče pogoje. Če damo eno vrsto na eno gojišče, bo videti tako, če jo damo na drugo gojišče, bo videti drugače – pa gre za isto vrsto. Fasciniralo me je, da je neki organizem tako dinamičen v svoji biologiji in hkrati tako prezrt, kot so glive takrat bile.
Glive na Marsu?
Pred leti ste sodelovali pri še eni znani študiji, ki je vlila upanje, da bi na Marsu lahko našli življenje. Uporabili ste bakterijo Deinococcus radiodurans, ki živi celo v jedrskih reaktorjih. Ugotovili ste, da bi pod površino Marsa, kjer vladajo zelo nizke temperature in visoko sevanje, takšna bakterija lahko preživela več kot 280 milijonov let. Zakaj tovrstne bakterije na Marsu še nismo našli?
Tukaj je več odgovorov. Eden je ta, da so dosedanje ekspedicije na Marsu naključno vzele vzorce in jih prinesle na Zemljo. Zdaj je sonda prvič pristala v delti reke, ki je nekoč tekla na površju, in sledi njenim iztokom. Če je nekoč tam bilo življenje, je bilo povezano z vodo.
Če življenje tam še vedno obstaja, pa se je pomaknilo v globino. Pod ledenim pokrovom je tekoča voda, ki je zelo slana.
Tovrstne sisteme imamo tudi na Zemlji, recimo jezero Vostok na Antarktiki, ki leži pod štiri kilometre in pol debelim ledenim pokrovom. Spodaj je slana voda. Vemo, da so v tisti vodi mikroorganizmi. Ne zato, ker bi do te vode že kdo zvrtal vrtino. Zvrtali pa so štiri kilometre globoko vrtino do ledu, v katerem se znajdejo mikroorganizmi, ki sicer živijo v vodi in se primrzujejo in odmrzujejo glede na klimatske pogoje. Tam so bili najdeni mikroorganizmi. In to so pogoji, ki jih pričakujemo na Marsu.
Na Marsu niso zvrtali vrtin in to tudi ni v načrtu. Tam, kjer se sonda vozi zdaj, bi lahko našli kvečjemu fosilne ostanke ali kemijsko spremenjene molekule.
Članek, ki ga omenjate, temelji na tem, da smo testirali, kako dolgo bi organizem zdržal, če bi bil v mrzlem in suhem okolju. Izračunali smo, da je za omenjeno bakterijo ta doba, za katero smo predvidevali, da je bistveno krajša, 280 milijonov let.
Zanimivo je, da tudi kvasovke, ki jih posušimo in zmrznemo, zdržijo bistveno dlje, kot smo nekoč mislili. Ne toliko kot Deinococcus radiodurans, vseeno pa tudi tukaj govorimo o milijonih let.
Edina mlada ženska med starejšimi gospodi. "Zaradi vprašanja sem ostala brez sape"
Jutri bomo obeležili 8. marec, dan žensk (pogovor je potekal v četrtek, op. a). Kako je biti ženska v akademskem svetu?
Kot ženska se moraš vedno nekoliko bolj dokazovati, to je dejstvo. Ženske smo v primerjavi z moškimi veliko bolj previdne, bolj realistične pri napovedovanju, kaj znamo in zmoremo. Že to je v sodobni družbi ovira.
Mlado žensko pogosto gledajo podcenjujoče. Na to vižo sem v življenju doživela marsikaj. Nikoli ne bom pozabila nekega sestanka na evropski ravni. Bila sem edina mlada ženska med samimi starejšimi gospodi. Do mene je prišel neki Nemec in me vprašal, kaj počnem tam in ali ne bi bilo bolje, da bi doma čuvala otroke, kot pa da hodim na takšne sestanke. Ostala sem brez sape, niti odgovoriti nisem mogla. Podobnih, nekoliko "milejših" situacij je bilo skozi leta še več. Mislim pa, da se je odnos do žensk v znanosti skozi zadnja desetletja vendarle izboljšal.
Kakšno je tvoje mnenje o tem?
Sodeluj v razpravi ali preberi komentarje